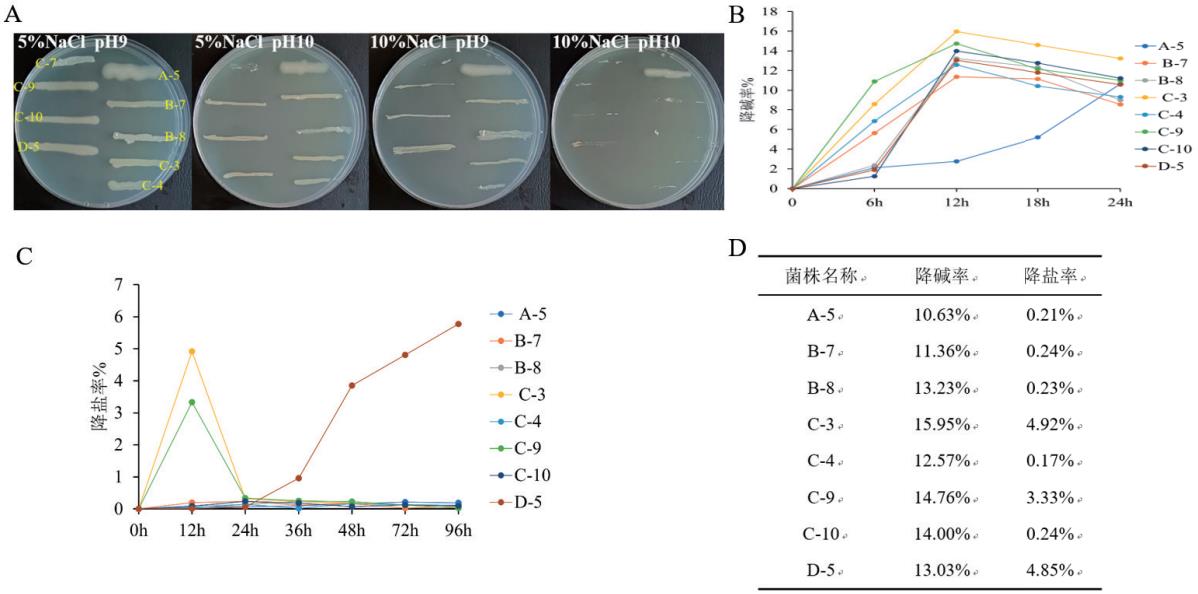

降盐碱菌的筛选及性能测定
王秋如 尹兆伟 田贺 张家伟 聂驿苏 刘飞 许亚文
济宁医学院
1 前言
土壤退化为盐碱地威胁着全球农业。干旱地区用含盐地下水灌溉、排水不当,叠加潮汐、海平面上升等影响,致使盐碱土壤增多、耕地减少。山东的重度盐碱地集中在西北沿海和黄河三角洲地区,因过度开垦致盐渍化加剧,此地治理意义重大。
我国干旱半干旱地区土壤盐碱化问题突出,盐渍化程度高、种类复杂、分布广且盐碱化速度加快。盐分超 0.5% ,作物根系吸水难,生长发育受阻、减产。盐碱度过高影响植物生长全过程。
目前土壤改良方法多样,物理改良如地面覆盖可抑制盐分表聚,但地膜有污染;化学改良效果显著但成本高、易污染;生物修复利用微生物和耐盐碱植物,能降低盐碱含量、改良结构,微生物肥料还可多方面提升土壤质量。
2 实验材料与方法
2.1 实验材料
山东省东营市垦利区盐场附近盐碱土壤,采集地下 5~15cm 非植物根际盐碱土壤,标记该为20 号。
2.2 实验方法
2.2.1 菌株分离纯化
取 10g 土样加无菌水震荡、静置后,取上清稀释为 10-1~10-3倍土壤浸出液,涂布于 pH=7、1%NaCl 的 LB 培养基平板, 37% 培养16~48 h,挑取单菌落划线编号制作菌种库。
2.2.2 耐盐碱菌株的筛选
将菌株接种于 pH9-5%NaCl、pH9- 10% 、 pH10-5% 和 pH10-10% 的4 种培养基上观察其生长状况。
2.2.3 菌株降碱率的测定
将上述耐盐碱菌接种于 pH9 的 LB 培养基中,28℃,180 转,24h,每隔 6 h 取发酵液,用 pH 计测量 pH 值,并依据以下公式计算降碱率。
菌株降碱效率 n= (初始pH- 最低 pH )/ 初始 pH×100%
式中:初始 pH 为灭菌后未接种菌株时液体培养基的酸碱度;最低pH 为反应过程中菌株降解后液体培养基最低酸碱度。
2.2.4 菌株降盐率的测定
将上述耐盐碱菌株接种于含 5%NaCl LB 的培养基中,28℃,180r/min,96h,每隔 12h 取发酵液,用盐度计测量各个时间的盐度,并依据下公式计算降盐率。
株降盐效率 n= (初始盐度- 最低盐度)/ 初始盐度 ×100%
2.2.5 菌株种属鉴定
将菌株接种于摇菌管中,培养 12~16h ,送至上海生工有限公司进行 16S rDNA 序列测定。通过 NCBI 和 MAGE7 进行序列比对,明确目标菌株的种属。
3 结果与分析
3.1 菌株盐碱耐受力的测定
随着 pH 值的不断升高,菌株的生长会受到抑制,不同菌株的耐碱能力不一。实验发现,大多数菌株在 pH 8-9 下仍可正常生长,当pH 升高至 10-11 时,部分菌株的生长严重受抑,但仍有 19 株菌种在pH11 时生长状况良好,即为耐碱菌。
将 36 株菌接种于盐浓度( 5% 、 10% 、 15% 、 20% )的培养基上,发现随着盐度的上升,存活的菌株越来越少,实验发现 16 株菌种在15% 盐浓度平板上依 旧生长良好,即为耐盐菌。
3.1.1 菌株对盐碱双胁迫耐受力测定结果
取土壤稀释液涂布于LB 平板上,获得79 株细菌的菌库,将菌株转至含 5%NaCl 的培养基上进行初筛,得到36 株耐盐菌种。
对上述菌株进行盐碱双胁迫实验,筛选耐盐碱的菌种。8 株在pH10-5% 和 pH9-10%NaCl 培养基上均生存较好,即为耐盐碱菌(图1A)。
3.2 菌株降碱、降盐能力的测定
将上述 8 株耐盐碱菌在 pH9 的 LB 培养基上生长 24h,每隔 6h测定 pH 值,并计算降碱率。8 株菌都均有将碱的能力,且多数菌在生长 12h 时,降碱率达到最高值,其中 C-3 和 C-9 的降碱效果最好,达到了 14% 以上(图1B)。
将 8 株菌株在 5% NaCl 的培养基上生长 3 天,每隔 12h 测一次培养基的盐度,并计算降盐率。如图 1C 所示,C-3 和 C-9 在 12h 时有降盐效果,但随培养时间延长,菌株的降盐效果会减弱;菌株 D-5在培养36h 时开始降盐,随培养时间的延长,降盐能力提高。
根据 24h 降碱和 96h 降盐时间进程实验的结果,计算每个菌株的最高降碱率和最高降盐率,最终统计结果表明菌株 C-3、C-9 和 D-5具有降盐碱的能力(图1D)。
3.3 菌株的种属鉴定
对 C-3、C-9 和 D-5 进行 16S rDNA 测序,使用 MEGA7 对其进行系统发育分析。发现三株菌株均为芽孢杆菌,其中 C-3 与 Bacillusstratosphericus 亲缘关系近;C-9 与 Bacillus zhangzhouensis 亲缘关系近;D-5 与 Bacillus pumilu 亲缘关系近。
4 展望
本研究聚焦东 营黄河三角洲重度盐碱地,在高碱、高盐及高盐碱多重胁迫下筛选耐盐碱菌株,测定 其降盐、降碱能力,成功锁定 3 株有降盐碱潜力的芽孢杆菌。不过研究尚有拓展空间, 未来可探究这 3株菌株在实际改良中的成效,明晰与其他改良举措的协同机 理,挖掘更多菌株资源。
参考文献
[1] 范王涛 . 土壤盐碱化危害及改良方法研究 [J]. 农业与技术 ,2020,40(23):114-116.
[2] 张蓉蓉 . 土壤盐碱化的危害及改良方法 [J]. 现代农业科技 ,2019,No.755(21):178-179.
[3] 蔡粟唯 . 外源钙对盐碱胁迫下沙枣的生理影响研究 [D]. 吉林农业大学 ,2022.
[4] 王成宝 , 杨思存 , 霍琳 , 姜万礼 . 地面覆盖方式对新垦盐碱地的抑盐和增产效果研究 [J]. 甘肃农业科技 ,2014,(11):42-45
[5] 赵娇 . 基于菌群改善促进盐碱地耐受性植物生长的研究 [D].山东大学 ,2020.
[6] 赵占周 . 土壤盐碱化对植物的影响及改良预防措施 [J]. 西北园艺 ( 果树 ),2020, 282(06):40-42.
[7] 李媛 . 农田盐渍化土壤敏感指示植物筛选及其指示研究 [D].东华大学 ,2009.
[8] 董合忠 , 辛承松 , 李维江 . 滨海盐碱地棉田盐度等级划分 [J].山东农业科学 ,2012,44(03):36-39.
作者简介:王秋如( 2004- ),女,汉,山东潍坊人,正主席,本科在读 生物信息学方向。
通讯作者:许亚文(1994-),女,汉 ,山东日照人,生命科学学院学生工作办公室 ( 团总支 ) 主任 ( 书记 ),硕士研究生,济 宁医学院,研究方向: 思想政治教育。